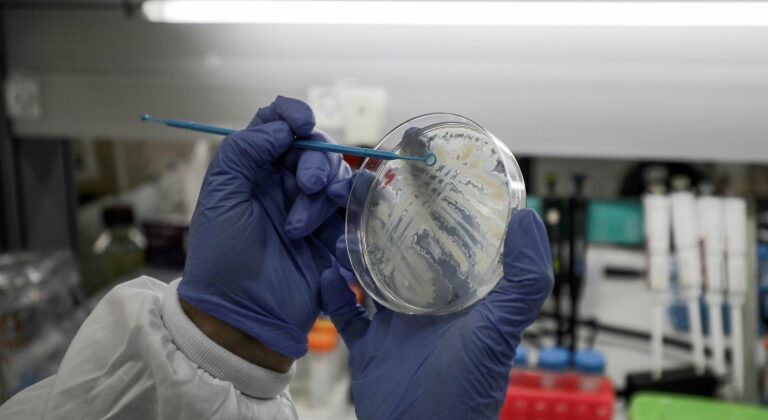
vaccino

Coronavirus: Trump tenta di rubare il vaccino all’Europa
Domenica sera il governo di Angela Merkel ha accusato gli Stati Uniti di Donald Trump di aver tentato di appropriarsi di un progetto per un vaccino contro il coronavirus sviluppato da un laboratorio tedesco e ha avvertito che avrebbe fatto di tutto per svilupparlo in Europa.
La Germania “non è in vendita”, ha protestato il ministro dell’Economia Peter Altmaier sul canale televisivo pubblico ARD.
E la sua controparte interna Horst Seehofer ha confermato la veridicità delle informazioni pubblicate lo stesso giorno dal quotidiano tedesco Die Welt nel tentativo del presidente americano Donald Trump di impadronirsi del laboratorio tedesco offrendogli una somma molto grande di soldi. “Posso solo dire che ho sentito diverse volte dai funzionari del governo che questo è corretto”, ha detto in una conferenza stampa.
Ha annunciato in seguito che il tema sarebbe stato sollevato lunedì dal “comitato di crisi” del governo responsabile della lotta contro l’epidemia di coronavirus, che fino ad oggi ha colpito quasi 5.000 persone in Germania e ha causato la morte di 12 persone.
Braccio di ferro
Al centro della resa dei conti: il laboratorio tedesco CureVac, situato a Tubinga, nel sud-ovest del paese. È uno di quelli in tutto il mondo che stanno lavorando a un vaccino Covid-19, ricevendo sovvenzioni dal governo tedesco. Afferma di essere “a pochi mesi di distanza” dalla possibilità di presentare un progetto per la validazione clinica.
Secondo il quotidiano tedesco, il presidente americano Donald Trump sta cercando di attirare milioni di dollari dagli scienziati tedeschi che lavorano su questo potenziale vaccino o per ottenere l’esclusività per il suo paese investendo nell’azienda.
Il vaccino sarebbe quindi “solo per gli Stati Uniti”, ha riferito al giornale una fonte vicina al governo tedesco. Un funzionario del governo degli Stati Uniti, intervistato da AFP domenica, ha dichiarato che il caso è stato “fortemente esagerato”.
Parlando a condizione di anonimato, ha detto che Washington ha parlato con più di 25 aziende farmaceutiche e ha assicurato che “qualsiasi soluzione che verrà proposta sarà condivisa con il resto del mondo”.
La realtà è, tuttavia, che il CEO della società tedesca è stato invitato personalmente dal Presidente il 3 marzo alla Casa Bianca per discutere di “un rapido sviluppo di un vaccino contro il coronavirus”, secondo un comunicato stampa di questo laboratorio.
Curiosamente, la società CureVac ha annunciato una settimana dopo la partenza a sorpresa di questo CEO, senza fornire una motivazione. Nel frattempo, la resistenza era chiaramente organizzata dalla parte tedesca, e in particolare all’interno dell’azienda interessata, di fronte alle inclinazioni americane.
Trump implicato
Il ministro tedesco dell’Economia ha quindi accolto con favore la “formidabile decisione” di CureVac di rifiutare i progressi americani. Un funzionario della compagnia, Franz-Werner Haas, da parte sua, ha confermato l’interesse di Washington ma ha affermato che non vi era stata alcuna “offerta di acquisto”.
Il presidente del Partito liberale tedesco (FDP), Christian Lindner, ha attaccato direttamente Donald Trump. “In un periodo elettorale tutti i mezzi sono ovviamente positivi per il presidente americano”, ansioso di assicurarsi la gloria del primo vaccino, ha affermato. “La lotta contro il coronavirus è un compito che riguarda tutta l’umanità, non c’è spazio per l’egoismo”, ha aggiunto.
“Dobbiamo evitare a tutti i costi la vendita esclusiva di un possibile vaccino negli Stati Uniti, ci sono limiti al capitalismo”, ha risposto un funzionario del Partito socialdemocratico, membro della coalizione del governo tedesco, Karl Lauterbach.
Berlino ha ritenuto “molto importante poter produrre vaccini in Germania e in Europa” e ha avvertito che potrebbe porre il veto a progetti di investimento in società nazionali ritenute strategiche.
“Il governo ha la possibilità di esaminare attentamente le acquisizioni di società tedesche da parte di stati stranieri, specialmente se è nell’interesse della sicurezza della Germania e dell’Europa”, ha avvertito il ministero dell’Economia.













